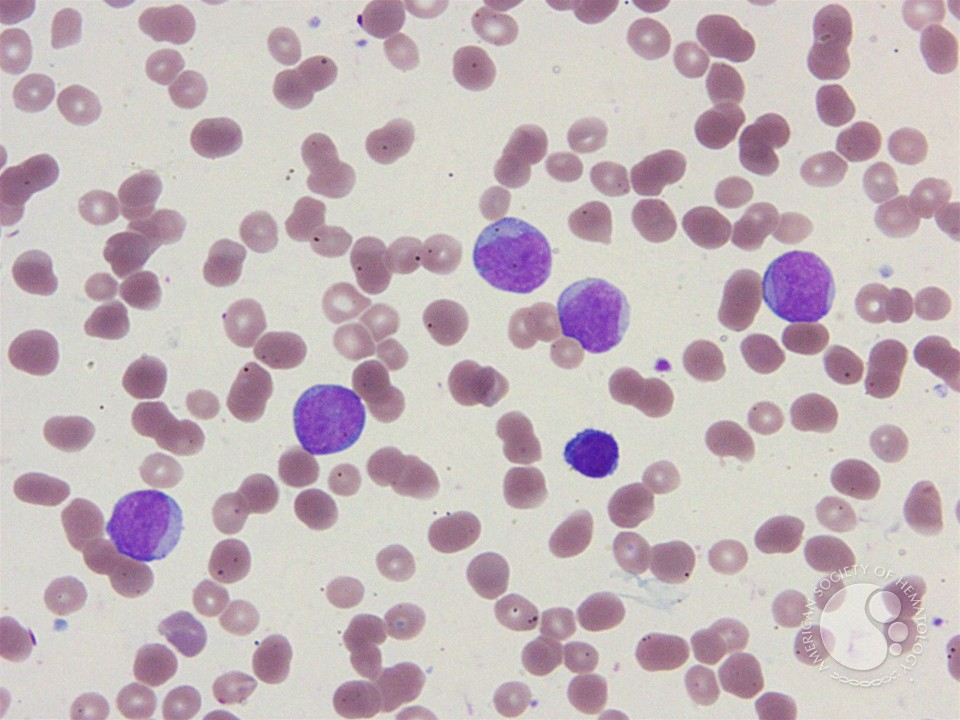
<p>blasts that are highly immature and agranular</p>
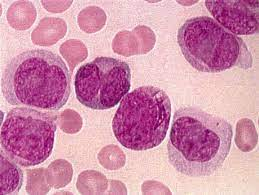
<p>myeloid cells with faint granules and tons of WBCs</p>
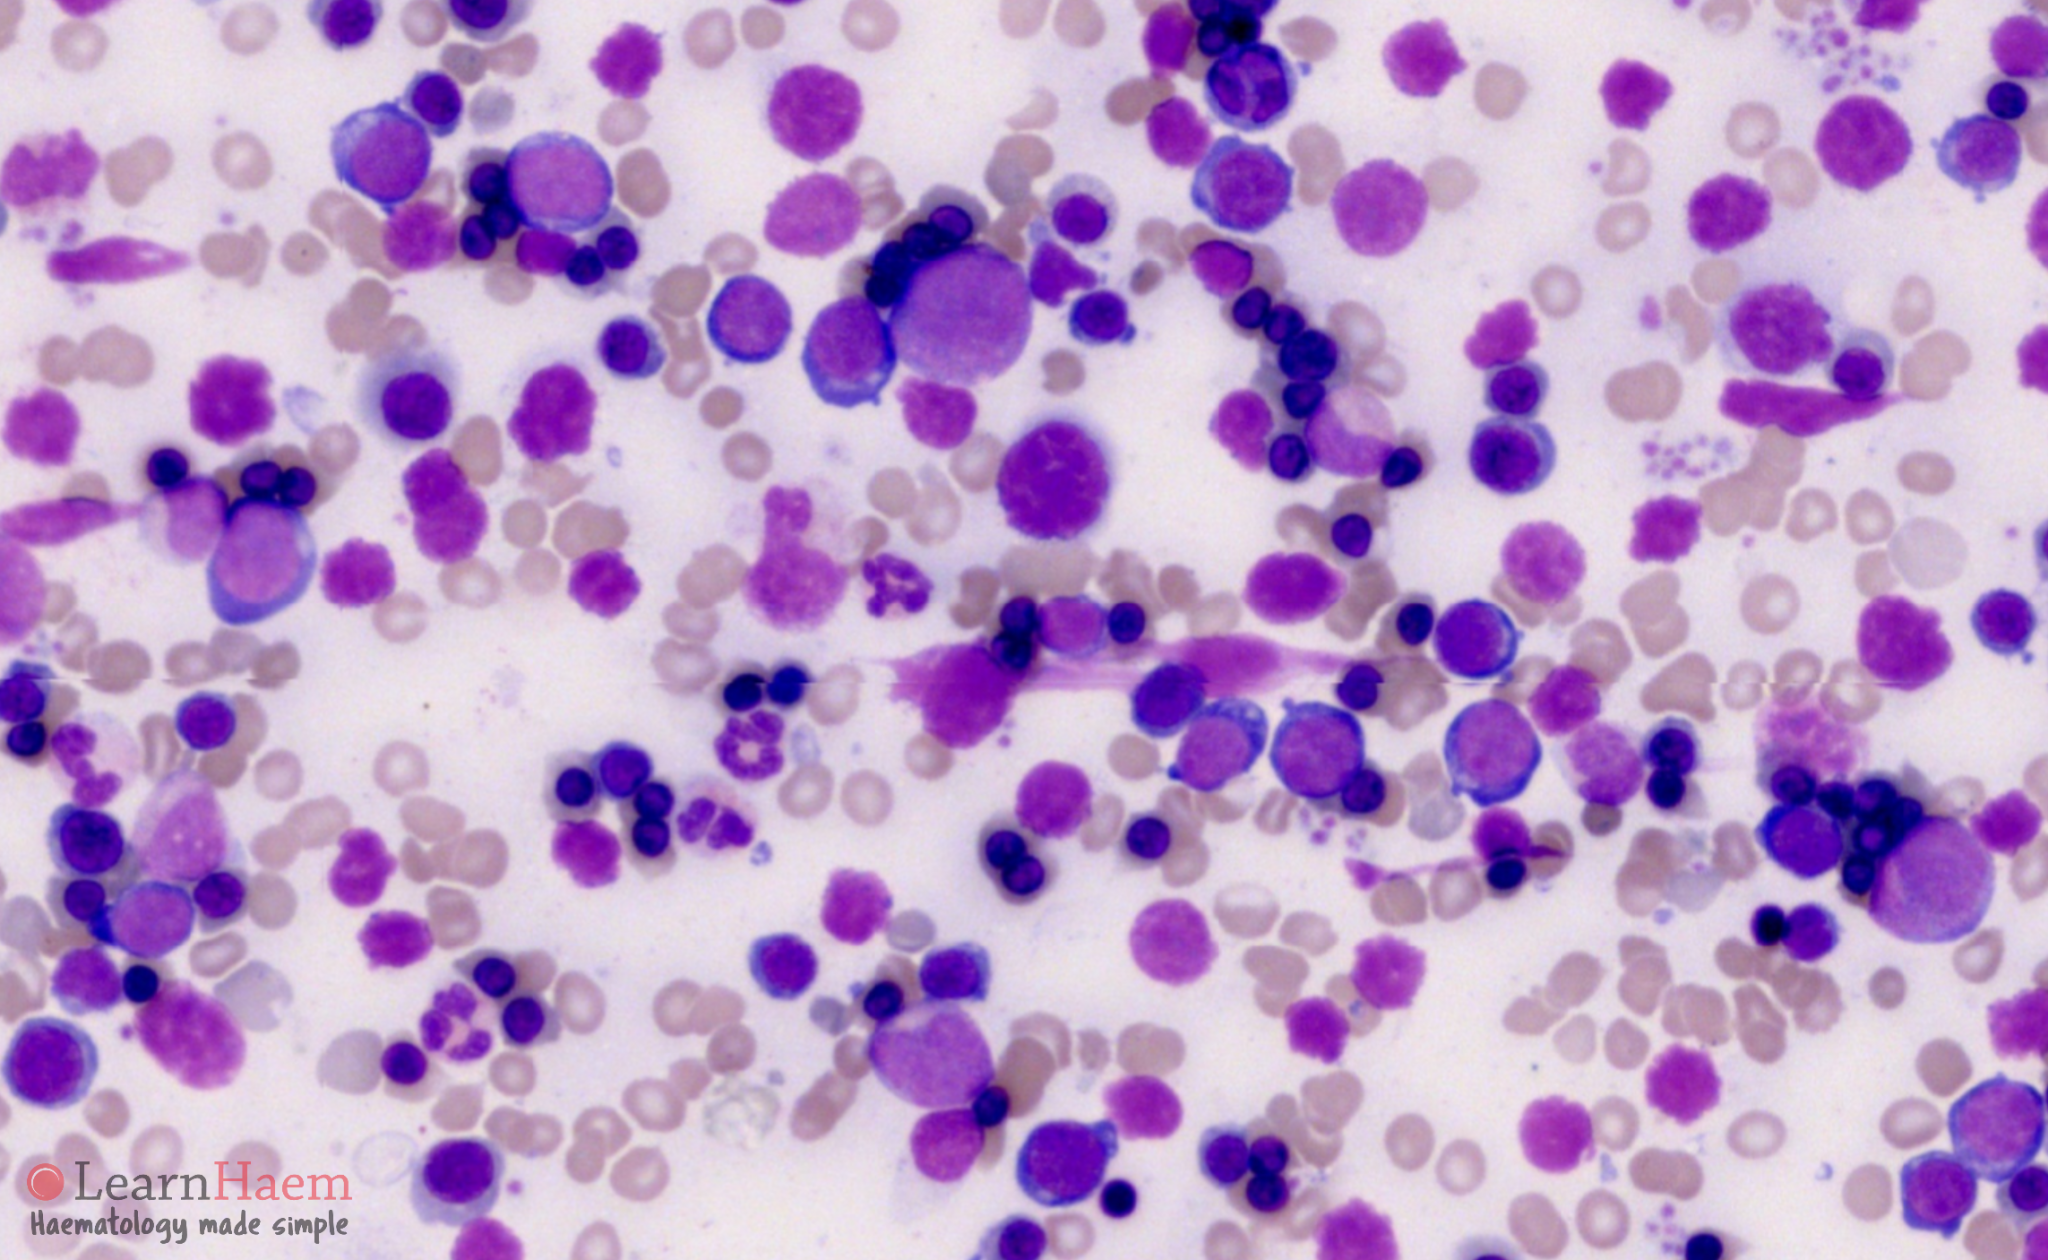
<p>irregular shaped blasts</p><p>irregular nucleoli</p><p>multinucleation</p><p>cytoplasmic vacuolation</p><p>lots of erythroblasts</p>

1/67
lecture 2
Name | Mastery | Learn | Test | Matching | Spaced | Call with Kai |
|---|
No analytics yet
Send a link to your students to track their progress
What is an acute myelogenous leukemia?
a stem cell disorder that has malignant neoplastic proliferation and a maturation block within hematopoietic cells
What populations do we typically see AML in?
elderly and infants
What are the four factors that contribute to AML occurrence?
age
exposure to chemo, radiation, or benzene
myelodysplastic syndromes
genetic abnormalities
What symptoms present with AML?
mucus membrane ulcerations
fatigue
anemia
hemorrhage
infections
Which cell population is typically elevated with AML?
WBC
What is the genetic abnormality of CML?
t(9,22)
What is the genetic abnormality of AML-M2?
t(8,21)
What is the genetic abnormality of AML-M3 or APL?
t(15,17)
What is the genetic abnormality of AML-M4?
16q
What is the genetic abnormality of AML-M5?
t(9,11) and t(8,16)
What is the gene product of t(9,22)?
Philadelphia chromosome, or ABL-BCR gene
With the philadelphia chromosome, is prognosis favorable or unfavorable in terms of survival rates?
favorable, survival rate is higher
What are the labs of AML in the peripheral blood?
high WBC counts
>20% blasts
auer rods (characteristic of myelogenous cell lines)
dysplasia of neutrophils
basophilia
What do PLT look like in AML?
giant, hypogranular, low in cell count
What do RBCs look like in AML?
more NRBC, inc. RDW, HJ bodies, basophilic stippling, pappenheimer bodies
What does the bone marrow look like in AML?
hypercellular with lots of blasts, bone destruction, hypercalcemia
What are the subtypes of AML?
AML-M0 to AML-M7
What substance is elevated in basophilic leukemia?
histamine
What is AML-M0?
AML with minimal differentiation
this means that we have lots of cells that are the same
What cell population is dominant in AML-M0?
blasts that are highly immature and agranular
What is the (1) MPO stain and (2) specific esterase stain reactions in AML-M0?
negative
negative
What is AML-M1?
AML without maturation
What cell population is dominant in AML-M1?
blasts with auer rods and a tiny bit of granulation

What is the (1) MPO stain and (2) specific esterase stain reactions in AML-M1?
weakly positive
weakly positive
What is AML-M2?
AML with mautration
What cell population is dominant in AML-M2?
blasts and maturing myeloids → 20 and 10% respectively
auer rods and granules present

What is the (1) MPO stain and (2) specific esterase stain reactions of AML-M2?
positive
positive
What is AML-M3?
acute promyelocytic leukemia
What two genes are fused in the t(15,17) translocation in AML-M3?
PML → tumor suppressor
RARa → retinoic acid receptor alpha
What is the result of the t(15,17) mutation?
represses genes involved in myeloid maturation
essentially it blocks myeloid cells from progressing past promyelocyte
What can we use to reverse AML-M3?
ATRA
What are the two forms of AML-M3?
hypergranular
microgranular
What is the hypergranular form of AML-M3?
hypergranular myeloid cells with auer rod bundles and azurophilic granules that contain procoagulant materials

What condition is associated with AML-M3?
DIC
What is microgranular AML-M3?
myeloid cells with faint granules and tons of WBCs
What is AML-M4?
acute myelomonocytic leukemia → monocyte and granulocyte precursor increase
What cell populations are dominant in AML-M4?
>20% monocyte
>20% neutrophil
plus their precursors

What condition is associated with AML-M4?
leukostasis, or WBC that clog up microvasculature
What are the symptoms of leukostasis?
headache, visual impairment, shortness of breath
its basically like a big WBC clump that blocks blood flow
What is AML-M5?
acute monocytic/monoblastic leukemia → all the stages of monocytes are here
What are the symptoms of AML-M5?
bleeds, gingival enlargement, CNS involvement
What condition is associated with AML-M5?
leukostasis
What are the two types of AML-M5?
M5a and M5b
What is AML-M5a?
tons of monoblasts in the marrow and the blood
What is AML-M5b?
tons of promonocytes and monocytes in the bone marrow and blood
What do the monocytes look like in AML-M5?
biggie
delicate reticular chromatin
1-2 nucleoli
folded nucleus
phagocytosis of RBC
pseudopodia → cytoplasm appendages
vacuoles

Which AML subtype has a high level of muramidase?
AML-M5
What is AML-M6?
erythroleukemia or Di Guglielmo syndrome
What two cell lines proliferate in AML-M6?
erythroid and granulocyte
What are the symptoms of AML-M6?
bleeds, hepatomegaly, splenomegaly, lymphadenopathy
What happens to the M:E ratio in AML-M6?
decreases to 1:4
What is the AML-M6 variant?
erythremic myelosis → where cell maturation arrests more rapidly of the erythrocyte precursors
see tons of erythroblasts
AML-M6 can turn into which other subtype of AML?
M1
What do the cells look like in AML-M6?
irregular shaped blasts
irregular nucleoli
multinucleation
cytoplasmic vacuolation
lots of erythroblasts
What is AML-M7?
acute megakaryoblastic leukemia, or acute myelofibrosiis
What cell population is dominant in AML-M7?
megakaryoblasts and megakaryocytes with blebs and reticulin fibrosis

Which two CD markers are positive in AML-M7?
CD41 and CD61
What is the FLT3 mutation?
a gene that codes for a tyrosine kinase, but is now mutated to allow leukomogenesis and spurs AML
If a person has the FLT3 mutation, what is the prognosis?
poor
Which medication can target the FLT3 mutation?
RYDAPT
What two CD markers ID granulocytes?
CD11b and CD33
Which CD markers ID monocytes?
Cd14, CD11b, CD16
What is remission?
the presence of <5% blasts in the marrow and a reduction of immature cells in the periphery
What is the chloroma leukemia?
form of AML that makes tumors of myeloblasts in the tissues
What substance is increased in chloroma? What color does it give off?
MPO increases → green colored tissue
What is eosinophilic leukemia?
a variant of AML or CML that causes immature eosinophils to infiltrate the tissues
What are the symptoms of eosinophilic leukemia?
cardiac failure, coughing, CNS issues
A hypereosinophilic syndrome caused by parasite infection will have what stage of eosinophils?
Mature